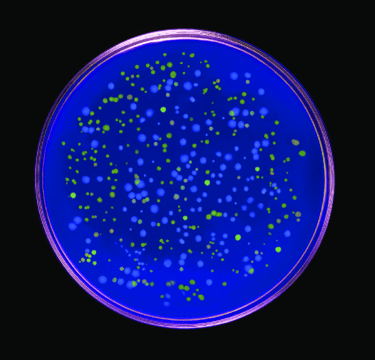
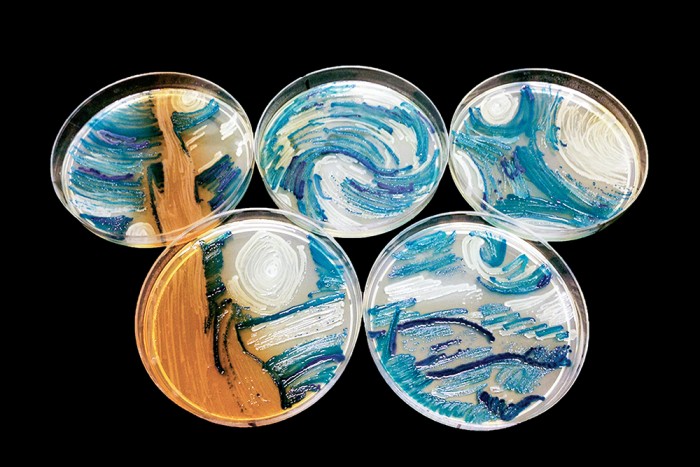
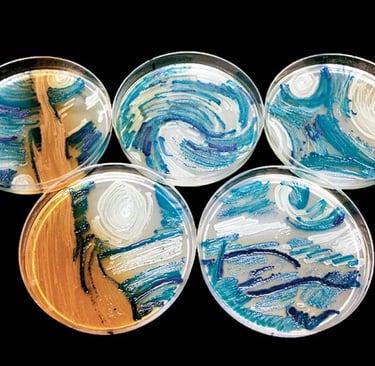

The Everyday Impact of Bioart featuring Kshamakshi Jain
Bio-art doesn't just build bridges—it’s a steadfast ally in sustainability. Discover Kshamakshi Jain's thoughts on bio-art and its role in promoting sustainable practices.
By Kshamakshi Jain, media and editing by Sunskritha R Shivaprasad
2/6/20254 min read
Art isn't merely a subject of vivid strokes of colors on a canvas; it extends way beyond that. It lives, it breathes, and it evolves. It is a mirror of humanity’s boundless advances.
Creativity has long been our subtend into the frame of curiosity, a path where innovation thrives. Similarly, dissolving the boundaries between biology and art gives birth to the realm of bio-art, where biological processes and artistry closely entwine. When science's techniques become the medium of artistic expression, new possibilities emerge. These challenge typical boundaries and invite creative thinkers to bridge the rigor of science with the imaginative freedom of art.
Bio-art fosters new ways of thinking regarding major issues that we face today such as sustainability. It promotes sustainability as bioartists usually use biodegradable substances and biomaterials such as tissue, blood, genes, and bacteria as their canvases. Since these materials naturally decompose or even regenerate, it reduces the environmental impact compared to conventional art supplies that leave behind long-lasting environmental footprints that eventually break down and often contribute environmental pollution.
The Everyday Impact of Bioart:
Bio-art bridges the worlds of science and creativity, bringing together the essence of life into artistic expression. Kshamkshi Jain, an 11th grader from Jaipur, India, shares her perspective on the significance of bio-art and its impact—whether in promoting sustainability or exploring deeper connections to nature.
Moreover, it allows people to look at these problems not just as scientific challenges, but as a part of the bigger picture. It's influence through creativity and innovation urges us to think critically about the tomorrow that we create by raising ethical and philosophical concerns through thought-provoking questions regarding the depth of humanity’s link to life and existentialism. It forces us to reflect on our relationship with nature and encourages people to consider more sustainable practices.
At its core, bio-art makes complex scientific ideas further accessible and relatable, helping more people to connect with topics that might otherwise seem intimidating or complex. Bioart can utilize concepts such as genetic engineering, synthetic biology, and environmental science via visual and sensory inputs which help demonstrate these intricate topics and make them more engaging. Through this perspective, we can see the beauty and urgency of various environmental issues, while also opening up to new ways when it comes to crafting impactful solutions. We have already seen how understanding the little organisms around us contribute to society—whether it's mapping out effective railway systems or utilizing bacteria to clean our environment. It invites us to think about the possibilities that we might never have considered.
Bioart doesn’t just serve to inform; it also provides therapeutic engagement, allowing people to reconnect with the living world in meaningful and transformative ways such as agar art. This artistic interaction provides a calming and reflective atmosphere that can sometimes help us heal in a different way. After all, mankind has always had a deep connection with nature.
Bio-art encourages us to spread creativity. It pushes us to think beyond the conventional periphery and helps us explore the countless novel opportunities and unique ideas that await us when science finally meets art.

Eduardo Kac's piece 'Genesis' that employs the use of recombinant DNA technology and genes. An artwork that uses decomposable material.
Melanie Sullivan's agar art inspired by Van Gogh's The Starry Night is an ode to how bioart illuminates the wonders of science, making it accessible and captivating for all.
Van Gogh's 1889 'The Starry Night'

About Kshamakshi Jain
Kshamakshi Jain (b. 2008) is a spirited student with a passion for exploring the intersections of creativity, science, and social responsibility. Her curiosity extends to diverse fields including sustainability, ethics, technological advancements, and the arts. Growing up in India, from a young age, Kshamakshi was inspired to address real-world challenges, focusing on creating meaningful change through practical, thoughtful solutions. This mindset has fueled her passion for science, inspiring her to explore ways that technology can not only solve complex problems but also benefit society as a whole.
Kshamakshi is a budding researcher and has worked on projects tackling environmental challenges and ethical issues. Her experiences have shaped a deep appreciation for the advancing role of science and art in shaping human understanding. One of her core missions is to spread awareness about the evolutionary capability of bio-art and encourage individuals conflicted between science and art to explore this field. She finds inspiration in how bio-art uses living organisms as a canvas to challenge conventional perspectives in both art and science, blending creativity with life sciences, symbolizing her passion for exploring new limits in both thought and artistic expression.


Contacts
sunskrithas19@gmail.com
Blog
© TheArtGene
sunskrithas@theartgene.com
Subscribe to our blog!
Updates bi-weekly every Sunday!